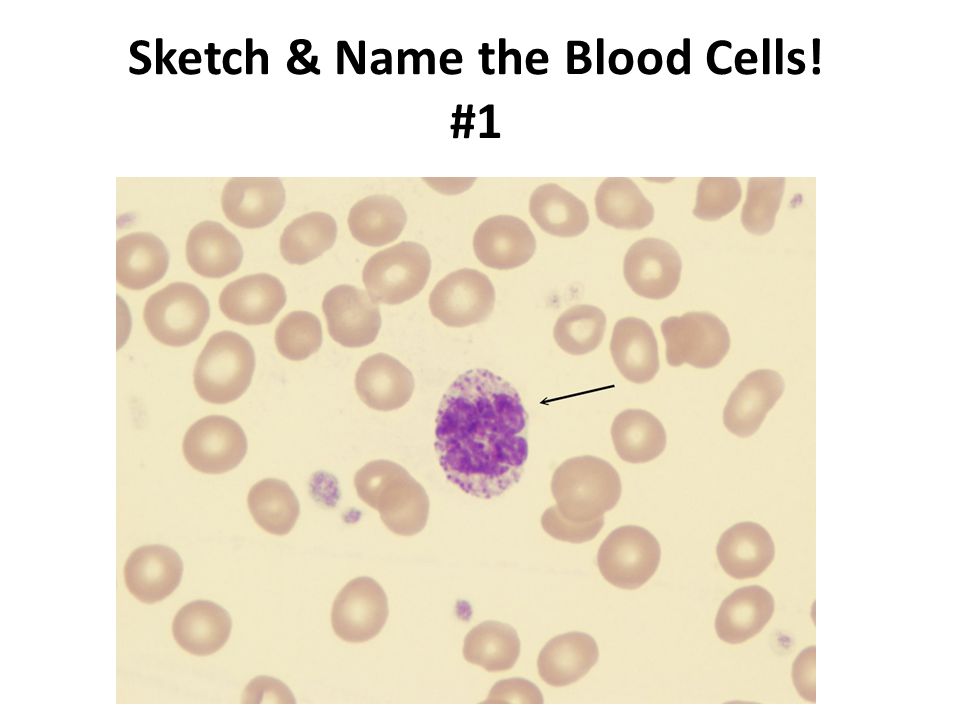
960x720 Types Of Blood Cells. Sketch Amp Name The Blood Cells! - Red Blood Cell Sketch

Red Blood Cell Sketch
Are you looking for the best images of Red Blood Cell Sketch? Here you are! We collected 37+ Red Blood Cell Sketch paintings in our online museum of paintings - PaintingValley.com.
ADVERTISEMENT
Most Downloads Size Popular
Views: 4600 Images: 37 Downloads: 9 Likes: 0

Biolegend Legendary ...
837x647 3 0

Red Blood Cell Diagr...
303x260 2 0

Guard Cells Ibug - R...
936x932 2 0

Animal Cells Gondar ...
207x138 1 0

Meredith Hoffman On ...
1200x1146 1 0

1 Minute Red Blood C...
480x360 0 0

Basic Red Blood Cell...
1024x768 0 0

Biology 2404 Aampp B...
500x500 0 0

Blood Cells And Bloo...
638x479 0 0

Blood Cells - Red Bl...
384x209 0 0

Blood Cells And Its ...
650x360 0 0

Bursting Red Blood C...
1632x1224 0 0

Cell Diagram 2 Blood...
1280x720 0 0

Cells - Red Blood Ce...
606x856 0 0

Components Of Blood ...
1575x1213 0 0

Composite Structure ...
303x303 0 0

Crude Sketch Of Red ...
1536x1340 0 0

Earthworm Circulatio...
728x614 0 0

Erythrocyte Red Bloo...
456x595 0 0

Experiment Cellular ...
1598x1266 0 0

Hataraku Saibou Whit...
576x774 0 0

Hitching A Ride On R...
400x319 0 0

Image About Cute In ...
570x719 0 0

Lymphocytes - Red Bl...
300x200 0 0

Optical Stretching O...
714x1018 0 0

Red Blood Cell Ae 38...
814x981 0 0

Red Blood Cell Color...
400x295 0 0

Red Blood Cells Func...
314x431 0 0

Red Draw A Diagram -...
1280x720 0 0

Red Blood Cell Distr...
440x275 0 0

Sickle Cell Anemia W...
723x633 0 0

Solved Sketch A Sing...
531x511 0 0

The Blood Cells - Re...
227x201 0 0
Types Of Blood Cells...
960x720 0 0

Wildehopps X White N...
774x1032 0 0

B) The Dimensions Of...
329x389 0 0

Red Blood Cell Sketc...
4000x4000 0 0
All rights to paintings and other images found on PaintingValley.com are owned by their respective owners (authors, artists), and the Administration of the website doesn't bear responsibility for their use. All the materials are intended for educational purposes only. If you consider that any of the materials violates your rights, and you do not want your material to be displayed on this website, please get in touch with us via "contact us" page and your copyrighted material will be immediately removed.































